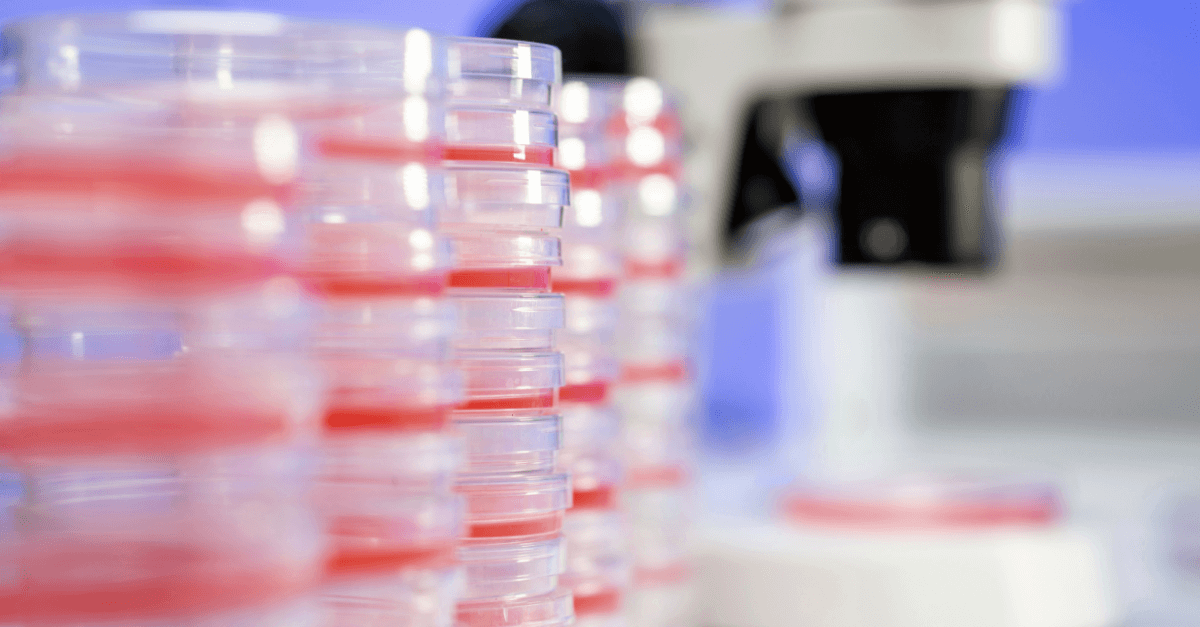

Clinisys™ Laboratory Solution
Clinisys technology drives the future
Clinisys™ Laboratory Solution is configurable cloud-based software that delivers greater efficiency, scalability, and heightened analytical insights.
It is designed to future-proof your lab informatics investment whilst reducing the total cost of ownership as well as helping you drive digital transformation and unlock the power of data in and beyond your labs.
Address current and future laboratory challenges
Keep your lab competitive with a solution that’s designed for the cloud, ready for artificial intelligence, and built to last.
With its intuitive, user-friendly interface, Clinisys Laboratory Solution meets market challenges by accelerating laboratory information system (LIS) and laboratory information management system (LIMS) workflows.
It also streamlines lab informatic processes—from sample management to reporting—reducing manual errors and improving productivity.
Growth
Drive growth and innovation by improving turnaround times, leveraging data for strategic investments and scaling seamlessly as needed.
Compliance
Efficiently manage regulatory requirements whilst ensuring quality in your lab. With full traceability and audit capabilities, you can comply with an extensive range of national and international regulations and protect your organisation’s reputation.
Efficiency
Maximise operational efficiency with automated and simplified processes across end-to-end lab operations, designed to streamline tasks and save valuable time and resources.
Standardisation
Establish a standardised approach across disciplines, geographies, and processes to help harmonise lab operations, facilitate data management, and eliminate data silos.
One Solution. One Platform. Configurable Offerings.
Transform your laboratory workflows and processes with configurable industry content packages that provide you with the discipline-specific sector and domain features needed to support essential laboratory processes in multiple major industries.

Our LIMS capabilities and approach
Our laboratory information management system (LIMS) solutions are built to drive laboratory modernisation, efficiency, and productivity for a range of sample-centric laboratory requirements across a diverse range of clinical and non-clinical workflows.
Whether you need a LIS or LIMS, we have you covered in one integrated platform, designed to help you advance your lab informatics capabilities in and beyond the lab, drive digital transformation, and unlock the power of data.
Our LIS capabilities and approach
Our laboratory information system (LIS) solutions help process, store, and manage patient data related to laboratory processes and testing for patient-specific specimens.
Next-generation laboratory information management systems
Clinisys Laboratory Solution offers a family of industry-specific content packages and universal capabilities that can advance any lab. We have a range of solutions that support healthcare, scientific and public health specialisms to ensure you and your teams can transform your lab workflows and processes for smarter working.
Thanks to flexible configurability and interoperability, Clinisys Laboratory Solution future-proofs your lab by enabling end-to-end workflow automation, unlimited connectivity, easy data structure availability, total quality control, and much more.
Clinisys™ Cellular Pathology Laboratory
Coming soon
A scalable cloud environment
As cloud-based software, Clinisys Laboratory Solution enables organisations to operate cost-effectively at any scale—from small, single-site labs to expansive, multi-country networks. Built on a data-centric platform, it supports seamless scalability across different sectors, disciplines, and specialisations.
Specialists, expertise in multiple industry sectors
Clinisys Laboratory Solution serves all sizes of lab, from scale-ups to enterprises, across regions and nations, and within multiple major industries and sectors.

Clinisys and healthcare
Clinisys, the #1 global clinical laboratory information systems provider*, continues to innovate with the launch of its single-platform solution for all pathology disciplines, including genetics. Our solutions cover the full specimen journey in healthcare from beginning to end.
*Signify Research, 2025.

Clinisys and contract services
Clinisys solutions support contract research and laboratory services organisations operating in all stages of the research, testing, commercialisation, and production lifecycle across diverse sectors and disciplines.

Clinisys and public health
Clinisys solutions support public health departments and laboratories to enable the efficient collection, testing, analysis, and reporting of data to accelerate rapid responses, track and monitor population-level changes, and inform long-term planning and health strategies.

Clinisys and environment
Clinisys solutions support environmental labs producing analytical data on biological, ecological, and physical sciences through testing soil, air, water, wastewater, and solids, as well as biomonitoring and microbiology. They offer the capabilities needed to streamline lab operations while delivering high-quality, reliable results to protect public health.

Clinisys and water
Clinisys solutions support the entire testing workflow, both out in the field and inside the lab. Enabling water quality labs to process samples efficiently and achieve regulatory compliance in multiple industries, including water and wastewater.

Clinisys and food & beverage
Labs in the food and beverage sector rely on Clinisys solutions to test and analyse food materials, identify contaminants, ensure ingredient stability, check cross-contamination, and investigate packaging materials and production processes.

Clinisys and crop sciences
In crop sciences, Clinisys solutions cover the scope of testing from gene to field and from crop to food, embracing consumer safety and environmental sustainability.

Clinisys and biotech
Coming soon.
Clinisys is developing capabilities to meet the diverse needs of labs conducting research and testing activities in the biotech sector. Our planned solutions will help integrate multiple scientific disciplines, test methodologies, instrumentation, and techniques.

Clinisys and pharma
Coming soon.
Clinisys is developing capabilities to help support the workflow and processes of labs operating in the pharmaceuticals industry by integrating multiple scientific disciplines, test methodologies, instrumentation, and techniques.
Get in touch
Experience the power of Clinisys Laboratory Solution and unlock the full potential of digital transformation for your lab. Get in touch to find out more.